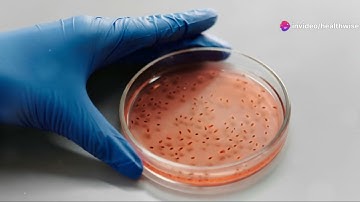
Essential Tips for Safe Specimen Transport

⬇ DOWNLOAD NOW
Kalau muncul iklan pop-up, tutup lalu klik tombol kembali
Download lagu Transporting of a Specimen secara gratis hanya untuk keperluan promosi. Dukung artis favorit kamu dengan membeli musik original di iTunes atau platform resmi lainnya.
 Transport of FNA samples
Transport of FNA samples
 Transportation Of The Specimens (MLT)
Transportation Of The Specimens (MLT)
 LOCAL TRIPLE PACKAGING SYSTEM (FOR SPECIMEN TRANSPORT)
LOCAL TRIPLE PACKAGING SYSTEM (FOR SPECIMEN TRANSPORT)
 90 Second Seminar: Specimen Transport Safety
90 Second Seminar: Specimen Transport Safety
 Specimen Transport And Storage Container&swab
Specimen Transport And Storage Container&swab
Essential Tips for Safe Specimen Transport
Essential Tips for Safe Specimen Transport
 Preparing urine specimens for transport
Preparing urine specimens for transport
 Transporting Specimens to the Lab
Transporting Specimens to the Lab